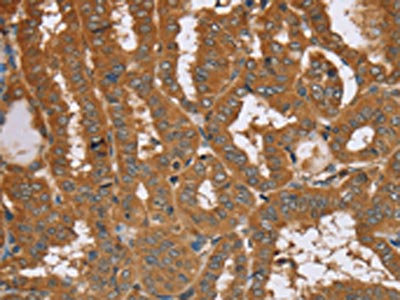

RAB14 Antibody
-
中文名稱:RAB14兔多克隆抗體
-
貨號:CSB-PA793696
-
規(guī)格:¥1100
-
圖片:
-
The image on the left is immunohistochemistry of paraffin-embedded Human breast cancer tissue using CSB-PA793696(RAB14 Antibody) at dilution 1/40, on the right is treated with synthetic peptide. (Original magnification: ×200)
-
The image on the left is immunohistochemistry of paraffin-embedded Human thyroid cancer tissue using CSB-PA793696(RAB14 Antibody) at dilution 1/40, on the right is treated with synthetic peptide. (Original magnification: ×200)
-
Gel: 10%SDS-PAGE, Lysate: 40 μg, Lane 1-2: Mouse brain tissue, Raji cells, Primary antibody: CSB-PA793696(RAB14 Antibody) at dilution 1/200, Secondary antibody: Goat anti rabbit IgG at 1/8000 dilution, Exposure time: 30 seconds
-
-
其他:
產(chǎn)品詳情
-
Uniprot No.:
-
基因名:
-
別名:bA165P4.3 antibody; F protein binding protein 1 antibody; FBP antibody; GTPase Rab14 antibody; RAB 14 antibody; RAB14 antibody; RAB14 member RAS oncogene family antibody; RAB14_HUMAN antibody; Ras related protein Rab 14 antibody; Ras-related protein Rab-14 antibody; RP11 165P4.4 antibody; Small GTP binding protein RAB14 antibody
-
宿主:Rabbit
-
反應(yīng)種屬:Human,Mouse,Rat
-
免疫原:Synthetic peptide of Human RAB14
-
免疫原種屬:Homo sapiens (Human)
-
標(biāo)記方式:Non-conjugated
-
抗體亞型:IgG
-
純化方式:Antigen affinity purification
-
濃度:It differs from different batches. Please contact us to confirm it.
-
保存緩沖液:-20°C, pH7.4 PBS, 0.05% NaN3, 40% Glycerol
-
產(chǎn)品提供形式:Liquid
-
應(yīng)用范圍:ELISA,WB,IHC
-
推薦稀釋比:
Application Recommended Dilution ELISA 1:1000-1:2000 WB 1:200-1:1000 IHC 1:50-1:300 -
Protocols:
-
儲存條件:Upon receipt, store at -20°C or -80°C. Avoid repeated freeze.
-
貨期:Basically, we can dispatch the products out in 1-3 working days after receiving your orders. Delivery time maybe differs from different purchasing way or location, please kindly consult your local distributors for specific delivery time.
-
用途:For Research Use Only. Not for use in diagnostic or therapeutic procedures.
相關(guān)產(chǎn)品
靶點詳情
-
功能:Involved in membrane trafficking between the Golgi complex and endosomes during early embryonic development. Regulates the Golgi to endosome transport of FGFR-containing vesicles during early development, a key process for developing basement membrane and epiblast and primitive endoderm lineages during early postimplantation development. May act by modulating the kinesin KIF16B-cargo association to endosomes. Regulates, together with its guanine nucleotide exchange factor DENND6A, the specific endocytic transport of ADAM10, N-cadherin/CDH2 shedding and cell-cell adhesion.
-
基因功能參考文獻(xiàn):
- Colorectal carcinoma (CRC) patients with elevated miR4903p amounts had prolonged overall survival. Ectopic expression of miR4903p in CRC cells resulted in decreased expression of RAB14, which was directly targeted by miR4903p, interacting with its 3'UTR. PMID: 29916545
- Phosphorylation of RCP at Ser(435) by Lemur tyrosine kinase-3 (LMTK3) and of EphA2 at Ser(897) by Akt are both necessary to promote Rab14-dependent (and Rab11-independent) trafficking of EphA2 which generates cell:cell repulsion events that drive tumour cells apart. PMID: 28294115
- RAB14 was identified as a direct target gene of miR-320a, according to the results of bioinformatics analysis and a luciferase reporter assay. Downregulation of RAB14 by RAB14-small interfering RNA inhibited the viability of Gastric Cancer cells, which was similar to the phenotype of miR-320a mimics. PMID: 28713899
- The results from this analysis indicated that Rab11a, Rab11c(Rab25) and Rab14 were expressed in a wide range of cell lines, including the human placental trophoblastic BeWo cell line. PMID: 28922401
- acst as oncogene and Induces proliferation of gastric cancer cells via AKT signaling pathway PMID: 28107526
- Rab14-specific siRNA-induced downregulation of Rab14 increases the sensitivity to cisplatin, while forced expression of Rab14 lacking 3'-UTR abrogated the pro-apoptotic function of miR-148a in renal cancer cells. miR-148a acts as a tumor suppressor and holds great potential for renal cancer therapy by directly targeting Rab14. PMID: 28098870
- PKCiota binds to Rab14 and that PKCiota requires Rab14 for its correct distribution in cells. As with Rab14, PKCiota protects claudin-2 from lysosomal degradation and, in consequence, modulates epithelial barrier. PMID: 25694446
- We find that Rab14 indeed binds to RCP, albeit with reduced affinity relative to conventional Rab11-FIP and Rab25-FIP complexes. However, in vivo, Rab11 recruits RCP onto biological membranes. PMID: 26032412
- RAB14 is a direct target of both MIR144 and MIR451. As MIR144 and MIR451 expression increased during human erythropoiesis, RAB14 protein expression decreased. RAB14 as a novel physiological inhibitor of human erythropoiesis. PMID: 25312678
- the miR-451/RAB14 interaction plays an important role in the enhancement of radiosensitivity in NPC cells. PMID: 25201065
- Data indicate that myosin Va interacted with multiple new Rab subfamilies including Rab6, Rab14 and Rab39B. PMID: 24006491
- Rab5a, Rab8a and Rab14 are major regulators of MT1-MMP trafficking and invasive migration of primary human macrophages. PMID: 23606746
- findings support a model for HIV-1 Env incorporation in which specific targeting to the particle assembly microdomain on the plasma membrane is mediated by FIP1C and Rab14 PMID: 23592992
- FAM116 and Rab14 therefore define an endocytic recycling pathway needed for ADAM protease trafficking and regulation of cell-cell junctions. PMID: 22595670
- Data suggest that targeting with the miR-451/RAB14 interaction might serve as a novel therapeutic application to treat NSCLC patients. PMID: 21358675
- Data show that Rab14 facilitates the delivery of sphingolipids required for bacterial development and replication from the Golgi to chlamydial inclusions. PMID: 21124879
- These findings suggest that Rab14 and Rab4 act sequentially, together with RUFY1. PMID: 20534812
- identifies the class I Rab11-FIPs as the first putative effector proteins for the Rab14 GTPase PMID: 19702578
顯示更多
收起更多
-
亞細(xì)胞定位:Recycling endosome. Early endosome membrane; Lipid-anchor; Cytoplasmic side. Golgi apparatus membrane; Lipid-anchor; Cytoplasmic side. Golgi apparatus, trans-Golgi network membrane; Lipid-anchor; Cytoplasmic side. Cytoplasmic vesicle, phagosome.
-
蛋白家族:Small GTPase superfamily, Rab family
-
數(shù)據(jù)庫鏈接: